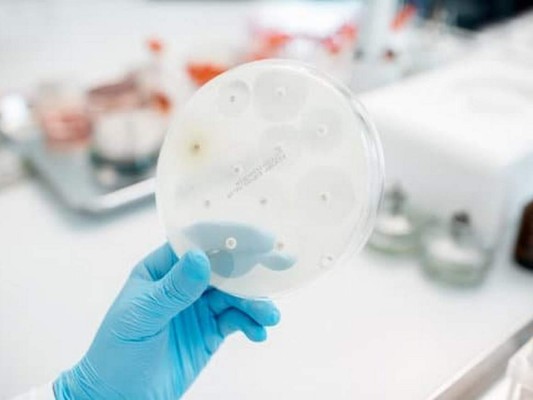
¿Son eficaces los antibióticos para prevenir o tratar el Covid-19?

TEGUCIGALPA, HONDURAS.- Los antibióticos no son eficaces contra el
coronavirus, así lo especifica la
Organización Mundial de la Salud (OMS).
El organismo, a través de su sitio detalla que los antibióticos son eficaces contra las bacterias, pero no contra los virus como es el caso del Covid-19.
Puesto que el mundo en la actualidad enfrenta una pandemia por el coronavirus, no deben utilizarse antibióticos ni para prevenirlo ni para tratar la infección.
El organismo, a través de su sitio detalla que los antibióticos son eficaces contra las bacterias, pero no contra los virus como es el caso del Covid-19.
Puesto que el mundo en la actualidad enfrenta una pandemia por el coronavirus, no deben utilizarse antibióticos ni para prevenirlo ni para tratar la infección.
Preguntas y respuestas: Todo lo que debes saber sobre el coronavirus
A los pacientes que dan positivo a los exámenes y son hospitalizados es posible se les administren antibióticos para que no contraigan infecciones bacterianas.
Por el momento, no se recomienda ningún medicamento específico para prevenir o tratar la infección por el nuevo coronavirus (2019-nCoV).
Es necesario atender adecuadamente a las personas infectadas por este virus para aliviar y tratar los síntomas que van desde leves a graves.
TAMBIÉN: Así ataca el coronavirus al organismo humano
Se están estudiando algunos tratamientos específicos que se probarán en ensayos clínicos. La OMS está ayudando a agilizar las labores de investigación y desarrollo con una serie de asociados.